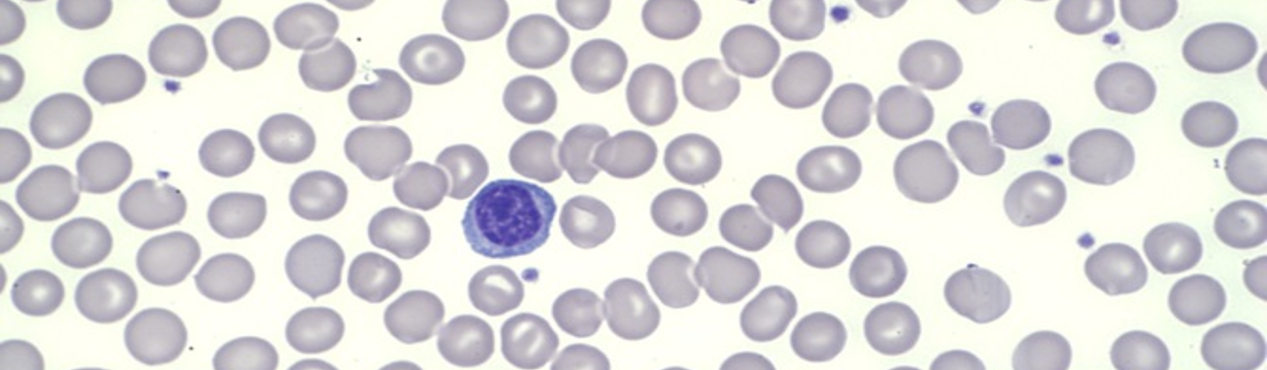

Opto-Mechanical Design of Digital Microscope for Blood Cell Imaging
Precision opto-mechanical subsystem developed from concept through validation for medical diagnostics instrumentation.
Introduction
This project involved the design and development of a precision mechanical system for applications requiring high stability, accuracy, and reliable performance. The design focused on achieving robust mechanical behavior while maintaining manufacturability and integration with surrounding systems.
This project demonstrates our expertise in opto-mechanical design and precision imaging system development. The system required careful integration of optical components, mechanical structures, and motion control to achieve high-resolution blood cell imaging
Engineering Challenge
The key challenge was balancing precision, structural rigidity, and manufacturability within system constraints. The design required careful consideration of tolerances, material selection, and assembly interfaces to ensure consistent performance.
Project Overview
Industry: Medical Diagnostics
Project Type: Opto-Mechanical + Product Development
Role: Full system design, integration, and validation
Design Approach
The system was developed using a structured engineering approach that included:
3D CAD modeling and detailed design
Tolerance analysis and GD&T application
Integration with electromechanical components
Design for manufacturability and assembly
What We did
Design of precision opto-mechanical XYZ positioning linear stage
Optical path design for 100X oil immersion imaging system
Integration of microscope subsystem into full blood analyzer
Prototype development, testing, and validation
Manufacturing documentation and handoff
Optical alignment and tolerance analysis
Results
The final system achieved high-resolution imaging performance with stable optical alignment and repeatable positioning. The design enabled reliable operation within a compact and manufacturable low cost architecture suitable for medical diagnostic applications
Need Help with Optical or Imaging Systems?
We provide expert opto-mechanical and imaging system design for complex engineering applications.
Based in California, we provide engineering consulting services to clients across the United States.

Achieved sub-micron optical and micron spatial resolution. stable under thermal vibration while maintaining manufacturability at scale.
